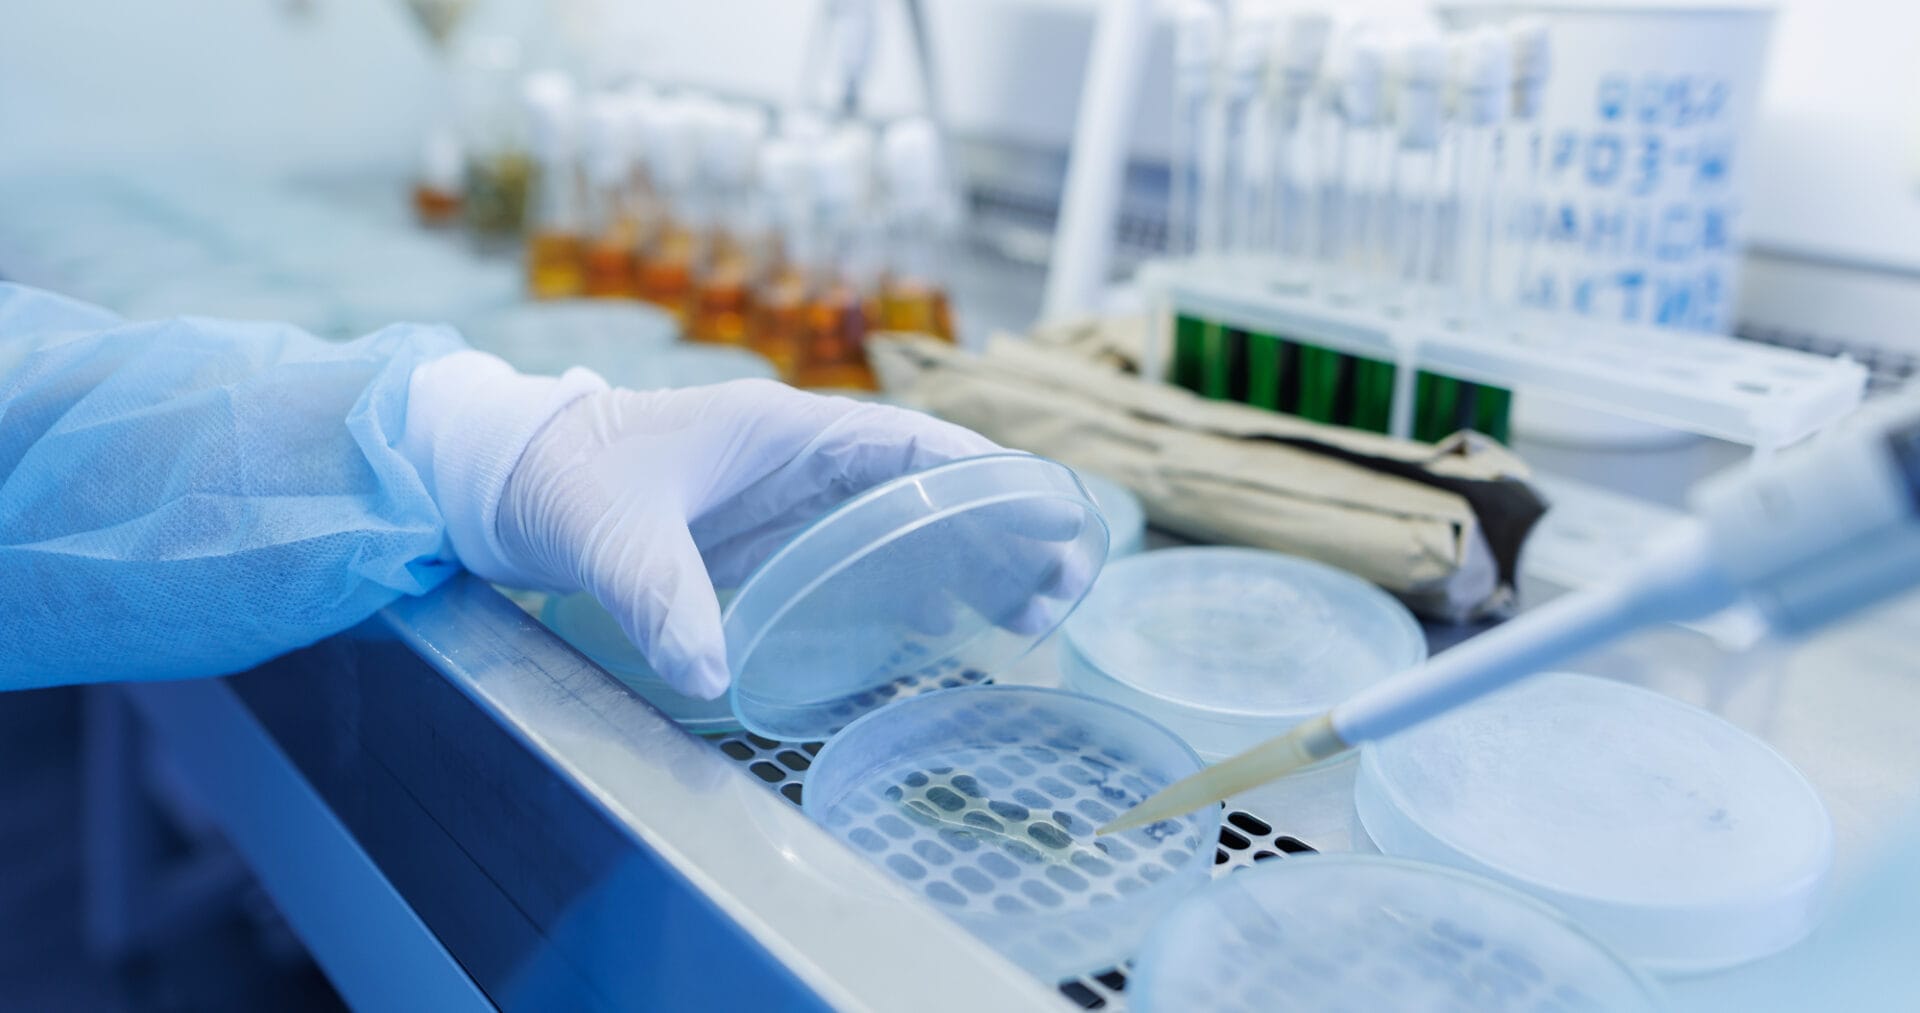
A gloved hand holds a petri dish while another hand uses a pipette in a laboratory setting with bottles and test tubes in the background.

Wholesale Consumables & Bulk PPE Supplier
Container-load procurement for healthcare, manufacturing, and foodservice industries.

We Negotiate Container-Load Pricing. You Keep the Savings.
For over 50 years, we’ve delivered container-load pricing on consumables and PPE that individual buyers can’t access alone. Through our network of 100+ certified manufacturers, we handle the complexity of high-volume procurement—negotiating favorable terms, ensuring compliance, and maintaining consistent supply—so you can focus on running your operations profitably
Whether you manage procurement for hospitals, manufacturing facilities, or foodservice operations, our expertise in global sourcing and supply chain management translates into one outcome: reduced costs, reliable supply, and simplified vendor management.
Expert Negotiators
Our partnerships with 100+ PPE manufacturers gives us the leverage to negotiate container-load pricing and wholesale rates that individual buyers can't access.
Vendor Neutral
We're loyal to your bottom line, not suppliers. Our independence ensures you get the best products at the best prices from domestic or global partners.
Guaranteed Savings
Our free procurement analysis identifies cost-reduction opportunities. We only recommend container-load procurement if significant savings potential exists—no pressure, just results.